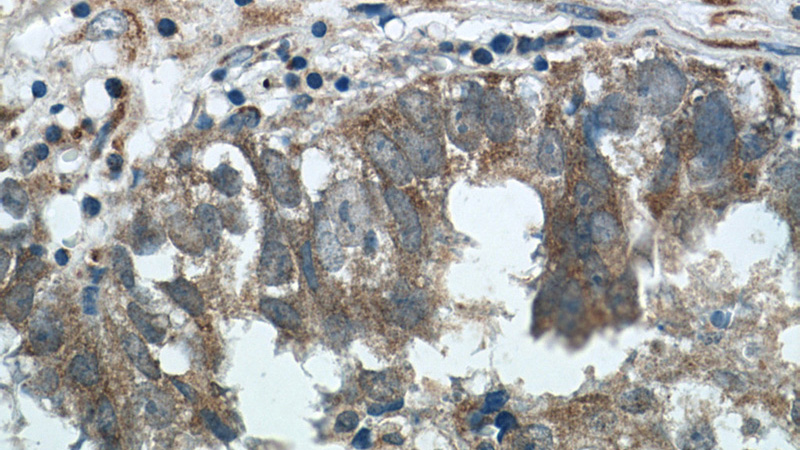
Immunohistochemistry of paraffin-embedded human breast cancer tissue slide using Catalog No:117040(ZFP36 Antibody) at dilution of 1:50 (under 40x lens)

-
Product Name
ZFP36 antibody
- Documents
-
Description
ZFP36 Rabbit Polyclonal antibody. Positive WB detected in mouse lung tissue, A549 cells. Positive IF detected in HepG2 cells. Positive IHC detected in human breast cancer tissue, human bladder tissue. Observed molecular weight by Western-blot: 40-45 kDa
-
Tested applications
ELISA, WB, IF, IHC
-
Species reactivity
Human,Mouse,Rat; other species not tested.
-
Alternative names
G0S24 antibody; GOS24 antibody; NUP475 antibody; Protein TIS11A antibody; RNF162A antibody; TIS11 antibody; TIS11A antibody; Tristetraproline antibody; TTP antibody; Zfp 36 antibody; ZFP36 antibody; Zinc finger protein 36 homolog antibody
-
Isotype
Rabbit IgG
-
Preparation
This antibody was obtained by immunization of ZFP36 recombinant protein (Accession Number: NM_003407). Purification method: Antigen affinity purified.
-
Clonality
Polyclonal
-
Formulation
PBS with 0.02% sodium azide and 50% glycerol pH 7.3.
-
Storage instructions
Store at -20℃. DO NOT ALIQUOT
-
Applications
Recommended Dilution:
WB: 1:200-1:2000
IHC: 1:20-1:200
IF: 1:10-1:100
-
Validations

mouse lung tissue were subjected to SDS PAGE followed by western blot with Catalog No:117040(ZFP36 antibody) at dilution of 1:300

Immunohistochemistry of paraffin-embedded human bladder tissue slide using Catalog No:117040(ZFP36 Antibody) at dilution of 1:50 (under 40x lens)
Immunohistochemistry of paraffin-embedded human breast cancer tissue slide using Catalog No:117040(ZFP36 Antibody) at dilution of 1:50 (under 40x lens)

Immunofluorescent analysis of HepG2 cells using Catalog No:117040(ZFP36 Antibody) at dilution of 1:25 and Rhodamine-Goat anti-Rabbit IgG
-
Background
The expression of many cytokines is regulated post-transcriptionally by factors that modulate mRNA transport, translation, and stability. Much of this regulation occurs by the binding and stabilizing, or destabilizing, of cytokine mRNAs by proteins that recognize adenosine and uridine-rich elements (AREs) in untranslated regions of target transcripts. Zfp36 is a mRNA-binding protein involved in post-transcriptional regulation of AU-rich element (ARE)-containing mRNAs. It was demonstrated to physically interact with the p65 subunit of nuclear factor-κB leading to decreased nuclear import and diminished transcriptional activation mediated by nuclear factor-κB. It acted by specifically binding ARE-containing mRNAs and promoting their degradation, and has a crucial role in the post-transcriptional regulation of tumor necrosis factor (TNF).
-
References
- Tan FE, Elowitz MB. Brf1 posttranscriptionally regulates pluripotency and differentiation responses downstream of Erk MAP kinase. Proceedings of the National Academy of Sciences of the United States of America. 111(17):E1740-8. 2014.
Related Products / Services
Please note: All products are "FOR RESEARCH USE ONLY AND ARE NOT INTENDED FOR DIAGNOSTIC OR THERAPEUTIC USE"
